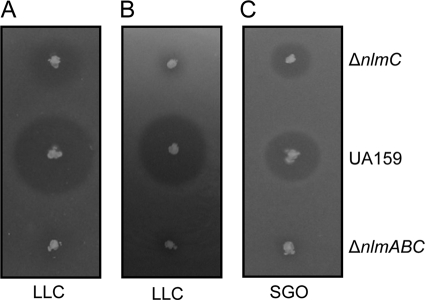

Abstract
Streptococcus mutans UA159, whose genome is completely sequenced, produces two nonlantibiotic mutacins, mutacin IV (encoded by nlmAB) and mutacin V (encoded by nlmC). In this study, we investigated the contribution of nlmA and nlmB to mutacin IV activity and demonstrated by performing genetic studies as well as by using semipurified molecules that, in contrast to a previous report, both of these genes are required for optimum mutacin IV activity. We also showed that mutacin IV is active against multiple Streptococcus species. In contrast, mutacin V displayed a narrower inhibitory range than mutacin IV. Our results suggest that mutacin IV and mutacin V may act synergistically to inhibit various organisms.
Bacteriocins are ribosomally synthesized small antimicrobial peptides secreted by a wide variety of bacteria to inhibit the growth of other bacteria. The antimicrobial activity of the bacteriocins may or may not be against species that are closely related to the producer organism (17). In most cases, producer organisms secrete multiple bacteriocins, each displaying a distinct inhibitory spectrum, either narrow or broad, to provide a competitive advantage by eliminating organisms that share the same ecological niche with the producer organism. Bacteriocins produced by lactic acid bacteria (LAB) are active against clostridia, listeria, and other pathogens; therefore, these bacteriocins have the potential to be used as antimicrobial therapy.
Streptococcus mutans, a lactic acid bacterium, is considered to be the primary causative agents of dental caries, commonly known as tooth decay (19). S. mutans resides in the dental plaque, a multispecies biofilm community that harbors over 600 different types of microorganisms (1). To inhibit the growth of competing bacteria and to establish a successful colonization in the plaque biofilm, S. mutans secretes a wide variety of mutacins that display a diverse inhibitory spectrum (3, 5). Based on the chemical structure, mutacins are generally classified into the following two groups: class I, the lantibiotics, and class II, the heat-stable nonlantibiotics (11, 18). Both lantibiotics and nonlantibiotics are synthesized ribosomally; however, lantibiotic peptides are posttranslationally modified and contain either a lanthionine or methyllanthionine ring structure as well as dehydrated amino acids (30). On the other hand, nonlantibiotics are unmodified peptides and consist of either one or two separate molecules (21).
A majority of the mutacins characterized to date belong to lantibiotics, such as mutacins I, II, III, BNy-266, SmbA/B, and 1140 (16, 24-27, 32). This group is also subdivided into two classes that are based on the primary amino acid sequences (12, 28). Subclass AI contains the most well-characterized peptides mutacin I and III, which are similar to nisin and subtilin. Subclass AII contains poorly characterized lantibiotics, such as mutacin II, that show similarity to lacticin 481 and salivaricin (12, 25, 28). The genome sequence of the reference strain S. mutans UA159 does not encode any genetic determinant for lantibiotic mutacins (2). However, this strain carries and produces at least two nonlantibiotics, mutacin IV and mutacin V (15). This strain also carries several other nonlantibiotics, like small peptides, with unknown functions (29).
Mutacin IV, which is active against the mitis group of oral streptococci (27), is a nonlantibiotic bacteriocin encoded by the nlm operon, which contains two genes, nlmA and nlmB, organized in tandem (2). The NlmA peptide consists of 44 residues, while the NlmB peptide consists of 49 amino acid residues. Both peptides contain signal sequences with well-conserved GG motifs, the site where peptidase cleavage occurs during export. NlmTE, a transporter complex, cleaves the signal sequence and mediates the export of these peptides (14). Each peptide also contains a single GxxxG motif, which is essential for bacteriocin activity due to its involvement in the formation of the helix-helix interaction (21).
Qi et al. (27) have recently purified mutacin IV activity from the culture supernatant of the UA140 strain and found that the active fractions contained both the NlmA and NlmB peptides. However, attempts to separate the complex of these two peptides into individual peptides by various high-pressure liquid chromatography (HPLC) protocols were unsuccessful (27). Thus, the contribution of NlmA or NlmB to mutacin IV activity has not been firmly established. In contrast, when Hale et al. (15) deleted the nlmB gene, the mutant strain apparently retained its mutacin activity and thus raised doubt about the role of NlmB in mutacin IV function.
S. mutans UA159 also secretes another nonlantibiotic peptide, mutacin V, which is a single peptide encoded by nlmC. The NlmC peptide is 52 residues long, with a signal peptide and three GxxxG motifs (15). This mutacin is also secreted by the NlmTE export system (14) and appears to have broad antimicrobial activity, ranging from mitis streptococci to lactococci and micrococcus (15). However, unlike mutacin IV, which was purified from the culture supernatant (27), mutacin V activity has never been purified.
In the present study, we focused strictly on the characterization of mutacins IV and V produced by the UA159 strain. We found that, contrary to the previous report, both the NlmA and NlmB peptides are required for optimum mutacin IV activity. Furthermore, we showed that mutacin IV activity has a broader inhibitory spectrum than previously described.
MATERIALS AND METHODS
Bacterial strains and growth conditions.
Escherichia coli strain DH5α was grown in Luria-Bertani medium supplemented, when necessary, with ampicillin (100 μg/ml), erythromycin (300 μg/ml), and kanamycin (100 μg/ml). Various streptococcus strains were routinely grown in Todd-Hewitt medium (BBL; Becton Dickinson) supplemented with 0.2% yeast extract (THY medium) at 30°C or 37°C. Lactococcus lactis MG1363 was grown in M17 medium supplemented with 0.5% glucose or THY medium at 30°C. When necessary, erythromycin (5 to 10 μg/ml), kanamycin (300 to 500 μg/ml), or spectinomycin (300 μg/ml) was added to the sterile growth media. Bacterial growth was monitored with a Klett-Summerson colorimeter as described previously (8).
Construction of nlmA-, nlmB-, and nlmAB-deleted strains.
The nlmA gene was deleted using a Cre-loxP-based method as previously described (6). First, ∼1.0-kb upstream and downstream regions were amplified with primer set Smu-NlmA-Nested-F1/EcoRV-Smu-NlmA-5′ Fusion and EcoRV-Smu-NlmA-3′Fusion/Smu-Nlm-Nested-R1 (Table 1 lists all the primers used), using S. mutans UA159 chromosomal DNA as the template. Two fragments were then digested with EcoRV, followed by ligation and cloning into the pGEM-T Easy cloning vector (Promega) to create pIB-D15. A Km-resistant cassette with flanking modified loxP sites was amplified from pUC4ΩKm (22) using the primers lox71-Km-F and lox66-Km-R (6) and cloned into the EcoRV-digested site to generate pIB-D17. Plasmid pIB-D17 was linearized with EcoRI and transformed into S. mutans UA159 as previously described (6). Transformants were selected on THY medium plates containing Km; one such transformant was named IBS-D2. To eliminate the loxP-Kmr cassette from the chromosome, IBS-D2 was transformed with pCrePA (6), which expresses the cre recombinase gene from a temperature-sensitive replicon (pWV01). Subsequently, Emr and Kms colonies were selected; those colonies contain pCrePA and lost the Km resistance gene from the chromosome. To cure the plasmid, one selected colony was inoculated in THY broth without antibiotics, grown overnight at 37°C, and plated onto THY agar. Ems colonies were isolated by replica patching; one such clone, named IBS-D4, was selected for further analysis. Deletion of the nlmA gene was verified by PCR analysis (Fig. 1) and confirmed by sequencing.
TABLE 1.
List of oligonucleotides used
| Primer | Sequence | Purpose |
|---|---|---|
| Smu-Nlm-Nested-F1 | GGCGTGACCATTCATGAAGCGAATGCC | Deletion of nlmAB |
| Smu-Nlm-Nested-F2 | GTGTTTCGTCTTTCATGGGATATTTAAAGGG | Deletion of nlmAB |
| Smu-Nlm-Nested-R1 | GCCTACAGCTAAGGCGATTAATACACC | Deletion of nlmAB |
| Smu-Nlm-Nested-R2 | GGCAGCAAAAAGTATCCAATAGACC | Deletion of nlmAB |
| Bam-Smu-NlmA-F | GCGGGATCCGGCAATCGAAGTTTTGGTGTAGAGGC | Cloning of nlmA and nlmAB |
| Xho-Smu-Nlm-R | GCGCTCGAGACAACTATTAGGCTTCGGCCTTAGC | Cloning of nlmA and nlmAB |
| EcoRV-Smu-NlmA-5′ Fusion | GCGGATATCGTTTGGCTGTCCATTACATC | Deletion of nlmA |
| EcoRV-Smu-NlmA-3′ Fusion | GCGGATATCGGGGACTCATTCGATCTCAT | Deletion of nlmA |
| Xho-NlmA-R | GCGCTCGAGTTTAATGAGATCGAATGAGTCCCCAAGTGC | Cloning of nlmA |
| Kan-D7-F | CTCCCGGCCGCCATGGCGGCCGC | Amplification of Kmr |
| Kan-D7-R | GGTCGACCTGCAGGCGGCCGCG | Amplification of Km |
| NlmB 5′ Fusion-R | GCCGCCATGGCGGCCGGGAGTTCTCCATTCCATTTAATTC | Deletion of nlmB |
| NlmB 3′ Fusion-F | CGCGGCCGCCTGCAGGTCGACCCCACACTAAATTGATATAATGG | Deletion of nlmB |
| loxP-KanF | CGATAACTTCGTATAATGTATGCTATACGAAGTTATGAGGATGAAGAGGATGAGGAGGCAG | cre-loxP-mediated clean deletion |
| loxP-KanR | CGATAACTTCGTATAGCATACATTATACGAAGTTATGCTTTTTAGACATCTAAATCTAGG | cre-loxP-mediated clean deletion |
| Bam-NlmC-F | GCGGGATCCCATTTTATATCTCCTTTTTTTG | Cloning of nlmC |
| Xho-NlmC-R | GCGCTCGAGTTAAATTACTAACCACAGGAAT | Cloning of nlmC |
| Smu-NlmC-F1 | GCAACTCCTAATAATAAAATAGAGGAGGCC | Amplification of nlmC |
| Smu1913-R | GATTTTTTTGAACGCTACTGTGTCTTTTTTAC | Amplification of nlmC |
| NlmA-F | ATGGATACACAGGCATTTG | RT-PCR for nlmA |
| NlmA-R | ATGAGATCGAATGAGTCC | RT-PCR for nlmA |
| NlmB RT- F | GGAATGGAGAATTAATACCATG | RT-PCR for nlmB |
| NlmB RT- R | GTGTGGAAAAACTACAGATCCA | RT-PCR for nlmB |
| Smu-GyrA-F | CTATGCTATGAGTGTTATTGTTGCTCGGGC | RT-PCR for gyrA |
| Smu-GyrA-R | GGCCATTCCAACAGCAATACCTGTCGCTCC | RT-PCR for gyrA |
FIG. 1.
Construction of nlmAB deletion mutants. (A) Schematic diagram of various deletion constructs. A Cre-loxP-based markerless gene deletion method was used for the construction of nlmA (IBS-D4)- and nlmAB (IBS-D3)-deleted strains. IBS-D3 was created by deleting the nlmAB operon by BbsI (Bs) and BstEII (EII) digestion and replacing it with a kanamycin resistance cassette (Km) that is flanked by loxP sites. The Km cassette was subsequently cured with Cre recombinase. An overlapping PCR method was used for the generation of IBS-D4. Two PCR fragments were generated by primers 1 and 2 and primers 3 and 6 and were fused with a loxP-flanked Km resistance cassette, which was later removed with Cre recombinase. Similarly, two PCR fragments were generated with primers 1 and 4 and primers 5 and 6 and fused with the loxP-flanked Km resistance cassette to create IBS-D10. The Km cassette was not cured in IBS-D10. Symbols: block arrows, open reading frames; bent arrows, promoters; arrowheads, primers; arrowheads with tails, primers with regions overlapping; white box, loxP site. (B) PCR verification of the constructs using primers 1 and 6. (C) Verification of plasmid-driven expression of nlmA and nlmB by semiquantitative RT-PCR. Total RNA was harvested from the indicated strains and subjected to cDNA synthesis. Five nanograms of cDNA from each strain were used for semiquantitative RT-PCR. The gyrA gene was included to ensure that equal amounts of RNA were used for all reactions. The data are representative of RT-PCR analyses resulting from at least two different RNA isolations.
For the construction of nlmB-deleted strain, overlapping PCR was used. First, ∼1.0-kb upstream and downstream regions were amplified with primer set Smu-NlmA-Nested-F1/NlmB 5′ Fusion-R and NlmB 3′ Fusion-F/XhoI-Smu-Nlm-R1, using S. mutans UA159 chromosomal DNA as the template. A Km-resistant cassette was amplified from pIB-D7 (created by cloning the Km cassette into pGEM-T Easy vector) using primers Kan-D7-F and Kan-D7-R, which have a 20-bp region overlapping with those of the two fusion primers used for amplification of the upstream and downstream fragments. Equal amounts of each of the three PCR products were used further as templates for overlapping fusion PCR with the primers Smu-NlmA-Nested-F2 and Smu-Nlm-Nested-R1. The amplified PCR product was purified and transformed into UA159 as previously described (6). Transformants were selected on THY medium plates containing Km, and one such transformant was named IBS-D10. Deletion of the nlmB gene was verified by PCR analysis (Fig. 1) and confirmed by sequencing.
Construction of the nlmAB-deleted strain, IBS-D3, was generated by the Cre-loxP-mediated unmarked gene deletion protocol and is described elsewhere (M. S. Hossain and I. Biswas, submitted for publication).
Construction of the nlmC-deleted strain in the nlmAB background.
To delete the nlmC gene, a fragment carrying the gene was amplified with ∼1.0-kb flanking regions from the genomic DNA of a nlmC-deleted strain (containing an Emr cassette; kindly provided by C. Levesque [University of Toronto]) (23) with primers Smu-NlmC-F1 and Smu1913-R. The amplified PCR product was purified and transformed into IBS-D3 as previously described (10). Transformants were selected on THY medium plates containing Em; one such transformant was named IBS-D13. Deletion of the nlmC gene was confirmed by PCR.
Construction of plasmids for complementation.
Plasmid pIB184-Km (Hossain and Biswas, submitted) was used as the vector for cloning. To clone the nlmA gene, a fragment containing the nlmA gene with the native promoter region was amplified from UA159 genomic DNA using the primers Bam-NlmA-F and Xho-NlmA-R. The amplified fragment was digested with BamHI and XhoI and cloned into BamHI-XhoI-digested pIB184-Km to generate pIB-D28. Similarly, the nlmB gene was amplified from IBS-D4 (ΔnlmA strain) (Fig. 1) using primers Bam-NlmA-F and Xho-Smu-Nlm-R. The amplified fragment was digested with BamHI and XhoI and cloned into BamHI-XhoI-digested pIB184-Km to generate pIB-D20. To clone the nlmC gene, a similar approach was used in which the PCR fragment was amplified from UA159 genomic DNA with primers Bam-NlmC-F and Xho-NlmC-R and cloned into pIB184-Km to generate pIB-D29. Complementing plasmids were initially verified by restriction digestion and confirmed by sequencing.
Purification of mutacin IV activity from the culture supernatant.
For purification of active mutacin IV molecules, wild-type UA159 or complemented strains (IBS-D3 with PnlmA, PnlmB, and PnlmAB, respectively) were inoculated into 10 ml Todd-Hewitt medium for overnight culture. A total of 4 ml of overnight culture was then inoculated into 200 ml of fresh Todd-Hewitt medium and incubated for 24 h at 37°C in a shaker incubator at 150 rpm. An equal volume of chemically defined media (7) was then added and incubated for another 24 h. Bacterial culture was then passed through a 0.45-μm membrane filter, followed by ammonium sulfate fractionation (80% saturation) as described by Yamamoto et al. (31).
Deferred antagonism bacteriocin assay.
After overnight growth on a THY agar plate, isolated colonies were stabbed into THY agar plates with a toothpick and grown overnight (∼18 h) at 37°C under microaerophilic conditions. Indicator strains were grown to stationary phase in THY broth, and 0.4 ml of the indicator culture was mixed with 10 ml of soft agar and overlaid on plates with the tester strains. Overlaid plates were then incubated overnight under the same conditions, and the diameters of the zones of inhibition around the mutacin-producing strains were measured. Three Streptococcus gordonii strains (DL-1, ATCC 10558, and M5) and one Streptococcus cristatus (BHT) were used as indicator strains for mutacin IV activity, while L. lactis MG1363 was used as the indicator strain for mutacin V activity.
RESULTS AND DISCUSSION
Mutacin IV activity requires both the NlmA and NlmB peptides.
To clarify the role of individual peptides in mutacin IV activity, we constructed individual single-deletion mutants and a double-deletion mutant. Since nlmA and nlmB are organized in an operon, insertion of any antibiotic resistance gene in nlmA would disrupt the normal expression of nlmB. To avoid this polar effect, we constructed a markerless nlmA mutant strain, IBS-D4, using the Cre-loxP system (Fig. 1). We also deleted the nlmB gene and replaced it with a kanamycin resistance cassette that lacks a transcription terminator at its 3′ end and was inserted in the same orientation as the nlmB gene, therefore eliminating the concern of a polar effect on the nlmA gene (Fig. 1). The downstream SMU.152 gene contains its own promoter, and its expression was not affected by the replacement, as measured by semiquantitative reverse transcription-PCR (RT-PCR) assay (data not shown). We also constructed a markerless nlmAB double-deletion mutant, IBS-D3, by using the Cre-loxP method (Fig. 1). These strains were evaluated for mutacin IV production against two indicator strains, S. gordonii and S. cristatus. These two indicator strains are sensitive to mutacin IV only when used against S. mutans strain UA159 (10). As shown in Fig. 2 A, deletion of either nlmA or nlmB drastically reduced the zone of inhibition against both of the indicator strains, although there was some residual mutacin IV activity present in both of the mutants, with the ΔnlmA strain displaying slightly more activity than the ΔnlmB strain. As expected, deletion of the nlmAB genes completely abolished the mutacin IV production.
FIG. 2.

Deferred antagonism assay for mutacin IV production by S. mutans strains. (A) Ability to produce mutacin IV by nlmA (IBS-D4)-, nlmB (IBS-D10)-, and nlmAB (IBS-D3)-deleted strains. (B) Complementation analysis of the ΔnlmAB strain (IBS-D3) with various levels of plasmid-derived expression of nlmA, nlmB, or nlmAB. For the mutacin IV assay, S. mutans cultures were stabbed into THY agar and incubated overnight at 37°C under microaerophilic conditions. The plates were overlaid with soft agar containing S. gordonii DL-1 (SGO) or S. cristatus ATCC 51100 (SCT) as indicator strains. The zones of inhibition of the indicator strains were evaluated after overnight incubation (*, strain also contains plasmid pIB184-Km). (C) Activity profile of semipurified mutacin IV from culture supernatant. Ammonium sulfate extractions from the clarified culture supernatant from the representative strains were tested for mutacin IV activity against the S. gordonii DL-1 indicator strain. A representative antagonism assay from at least two independent extractions is shown. WT, wild type.
To confirm that both the NlmA and NlmB peptides are necessary for the observed bacteriocin activity, we used a complementation assay. The IBS-D3 strain was complemented with plasmids carrying nlmA, nlmB, or nlmAB and tested against the same two indicator strains. We also used IBS-D3 carrying only the vector plasmid as a control. Expression of nlmA, nlmB, and nlmAB from the plasmids was confirmed by semiquantitative RT-PCR analysis (Fig. 1C and data not shown). To facilitate the selection of the complementing plasmids with antibiotics, the indicator strains were transformed with the same vector plasmid. As shown in Fig. 2B, expression of the nlmAB genes successfully restored mutacin activity, whereas expression of the nlmA gene alone did not restore the mutacin activity compared with that restored by the wild type. Surprisingly, we found that expression of nlmB could restore the mutacin production to some extent; however, the activity was much less than that restored by the wild-type strain. Thus, taken together, our results suggest that optimum mutacin IV activity requires both the NlmA and NlmB peptides.
To confirm our observation, we purified the active molecules by ammonium sulfate precipitation from the culture supernatant. The purified molecules were tested for mutacin IV activity against the S. gordonii indicator strain. As a positive control, we also included the wild-type UA159 strain. As shown in Fig. 2C, deletion of the nlmAB genes completely abolished the mutacin activity. Although the overproduction of either nlmA or nlmB restored the mutacin activity, overproduction of both of the peptides significantly augmented the activity, confirming that optimum mutacin IV activity requires both the NlmA and NlmB peptides.
Although it is not entirely clear why Hale et al. (15) failed to observe any function for the NlmB peptide, it is possible that the inhibition assay and the growth media used by those authors were different from the ones used here. In our case, a direct overlay of the indicator strain was used to avoid the chloroform vapor. Our data also suggest that overproduction of the NlmB peptide is able to inhibit the growth of the indicator strains. We speculate that NlmB itself can form a homodimeric transmembrane helical structure needed for the activity since it also contains the GxxxG motif. In this regard, mutacin IV is similar to lactacin F, which is also a dipeptide bacteriocin composed of LafA and LafX. The individual peptides display inhibiting activity, although the efficiency is lower than when both the peptides are used together (4). Alternatively, in the absence of NlmA, NlmB can form the heterodimeric helix-helix structure with other bacteriocin-like peptides such as SMU.283, which shows high homology to NlmA. Further in vitro studies with purified or synthetic peptides may tell us whether NlmB can form such structures in vivo.
Bacteriocins produced by S. mutans UA159 are active against Streptococcus pyogenes.
S. pyogenes, a pathogenic streptococcus that also resides in the oral cavity, was shown by Hale et al. to be inhibited by mutacin IV (15). To refine and expand the observation, we tested our mutant strains against three S. pyogenes strains, JRS4, K56, and AM3, belonging to three different serotypes, M6, M12, and M3, respectively. As shown in Fig. 3 A, deletion of nlmA, nlmB, or nlmAB caused a significant reduction in the zone of inhibition formation against the S. pyogenes strains. Although the reduction was not as drastic as that observed against the S. gordonii strain, nevertheless, the reduction was easily measurable. We then tested the effect of mutacin V against S. pyogenes strains. For this, we used either the nlmC mutant or the nlmAB nlmC triple mutant strains. As shown in Fig. 3B, deletion of nlmC also leads to a reduction of zone of inhibition compared with that of the wild type. However, the reduction was higher in the case of the nlmC mutant than that in the case of the nlmAB mutant, suggesting that mutacin V is more active against S. pyogenes than mutacin IV (Fig. 3B, compare ii and iv). As expected, the zone of inhibition produced by the triple mutant was further reduced, although the mutant produced a very small but noticeable zone of inhibition. To confirm our results, we complemented the triple mutant strain (IBS-D13) with plasmid-based nlmAB or nlmC. As shown in Fig. 3C, expression of the nlmAB genes in IBS-D13 from a complementing plasmid completely restored the mutacin IV activity (compare i and ii). Similarly, expression of nlmC in IBS-D13 also restored mutacin V production; however, the efficiency of complementation was below the expected level (Fig. 3B, compare ii and iii). Taken together, our results suggest that both mutacin IV and mutacin V inhibit S. pyogenes and that their effect is synergistic.
FIG. 3.
Bacteriocin activity of S. mutans UA159 against group A streptococcus. (A) Inhibitory effect of mutacin IV on S. pyogenes strain JRS4. i, ΔnlmA strain; ii, ΔnlmB strain; iii, ΔnlmAB strain; iv, strain UA159. (B) Activity of mutacin IV- or V-deficient mutant strains against S. pyogenes JRS4. i, ΔnlmABC strain; ii, ΔnlmAB strain; iii, UA159; iv, ΔnlmC strain. (C) Complementation analysis of the ΔnlmABC strain. i, UA159/pIB184-Km; ii, IBS-D13/pIB D19 (nlmAB); iii, IBS-D13/pIB-D29 (nlmC); iv, IBS-D13/pIB184-Km.
Growth of the indicator strain dictates sensitivity to mutacin.
It has been previously shown that L. lactis is not inhibited by mutacin IV (15). When we tested our mutant strains against L. lactis MG1363, we observed that depending on the growth stage of the culture, mutacin IV activity could inhibit L. lactis growth. When mid-exponential-growth-phase L. lactis culture was used for the overlay, we observed that the ΔnlmC strain produced a noticeable zone of inhibition that was absent when the indicator culture used was from the stationary growth phase (Fig. 4 A and B). As expected, the triple mutant strain IBS-D13 did not produce any zone of inhibition irrespective of the growth stage of the indicator strain. Thus, mutacin IV appears to inhibit L. lactis growth.
FIG. 4.
Mutacin activity against other species. Derivatives of S. mutans UA159 were tested for inhibitory activity against L. lactis (LLC) (A and B) or S. gordonii (SGO) (C). For L. lactis, either freshly grown (A) or 1-day-old (B) cultures were tested for growth inhibition.
It is known that mutacin IV inhibits S. gordonii growth, but very little is known about the inhibitory spectrum for mutacin V. Therefore, we tested the ΔnlmC and ΔnlmAB ΔnlmC (IBS-D13) strains against S. gordonii culture that was grown to early stationary phase. As shown in Fig. 4C, the zone of inhibition produced by the ΔnlmC strain was drastically reduced compared to that produced by the wild-type strain. On the other hand, the ΔnlmAB ΔnlmC mutant strain produced virtually no zone of inhibition against S. gordonii. These results indicate that mutacin V also can inhibit the growth of S. gordonii in addition to that of L. lactis. Interestingly, when we used the ΔnlmAB strain, we observed very little mutacin activity against the S. gordonii indicator strain, suggesting that mutacin V alone cannot work efficiently; the presence of mutacin IV augments the inhibitory activity of mutacin V. In this regard, these two mutacins seem to work synergistically.
Inhibition of various streptococci by mutacin produced by S. mutans UA159.
Because we found that both mutacin IV and mutacin V have wider ranges of inhibitory spectra than expected, we tested several other Streptococcus spp. belonging to all phylogenetic subgroups for sensitivity to both mutacins (Fig. 5). For this, we used the same two mutant strains, IBS-D3 and IBS-D13, as well as the ΔnlmC strain, and tested them against 18 different Streptococcus spp. As shown in Table 2, mutacin IV inhibited growth of all the streptococcus subgroups, except the mutans group and S. pneumoniae, a mitis subgroup species. On the other hand, mutacin V inhibited growth of only five streptococci belonging to four subgroups (pyogenic, anginosus, mitis, and bovis). However, we found that not all species belonging to a particular subgroup were susceptible to mutacin V. For example, in the case of the pyogenic subgroup, only Streptococcus iniae and S. pyogenes were inhibited by mutacin V. Thus, we conclude that mutacin V has a narrower inhibitory spectrum than mutacin IV, which has a much broader inhibitory spectrum. Because we observed different inhibitory spectra for mutacin IV and mutacin V, it argues that the mechanisms of immunity against these two mutacins are different.
FIG. 5.
Mutacin activity against various streptococci. Phylogenetic classification of various streptococci based on 16S rRNA sequence analysis. The species tested for sensitivity against mutacin IV (circle) or mutacin V (square) produced by S. mutans UA159 are shown.
TABLE 2.
Inhibitory spectrum of S. mutans UA159
| Species (indicator strain[s])b | Group | Zone of inhibition diam (mm)a |
|||
|---|---|---|---|---|---|
| Wild type | Strain carrying: |
||||
| ΔnlmAB | ΔnlmC | ΔnlmABC | |||
| S. uberis (UT387) | Pyogenic | 22 ± 2 | — | 22 ± 2 | — |
| S. agalactiae (NEM306) | Pyogenic | 16 ± 1 | — | 13 ± 1 | — |
| S. iniae (K388) | Pyogenic | 14 ± 1 | 13 ± 1 | 9 ± 1 | 5 ± 0.5 |
| S. pyogenes (JRS4, AM3, K56) | Pyogenic | 24 ± 1 | 14 ± 1 | 17 ± 1 | 10 ± 1 |
| S. anginosus (CI) | Anginosus | 23 ± 1 | 16 ± 1 | 17 ± 1 | 5 ± 0.5 |
| S. constellatus (CI) | Anginosus | 25 ± 2 | — | 17 ± 1 | — |
| S. cristatus (ATCC 51100) | Mitis | 14 ± 1 | 4 ± 0.5 | 11 ± 1 | 4 ± 0.5 |
| S. gordonii (DL-1, ATCC 10558, M5) | Mitis | 17 ± 1 | — | 17 ± 1 | — |
| S. pneumoniae (ATCC 6303) | Mitis | 10 ± 1 | 10 ± 1 | 10 ± 1 | 10 ± 1 |
| S. sanguinis (SK36) | Mitis | 10 ± 1 | — | 9 ± 1 | — |
| S. salivarius (ATCC 25975) | Salivarius | 8 ± 1 | — | 8 ± 1 | — |
| S. bovis (TX20005) | Bovis | 9 ± 1 | 4 ± 0.5 | — | — |
| S. downei (ATCC 33798) | Mutans | — | — | — | — |
| S. sobrinus(6715) | Mutans | — | — | — | — |
| S. criceti(AHT) | Mutans | — | — | — | — |
| S. mutans (UA159, UA130, GS-5) | Mutans | — | — | — | — |
| S. ratti(BHT) | Mutans | — | — | — | — |
—, none or a <4-mm zone of inhibition. Values are means ± standard deviations resulting from at least three independent experiments performed in duplicates.
Three different strains for three streptococci were tested, as indicated. CI, clinical isolates.
In conclusion, our study showed that mutacins produced by S. mutans UA159 have much broader inhibitory spectra than expected. We also found that maximum mutacin IV activity requires both the NlmA and NlmB peptides. In this regard, mutacin IV truly belongs to class IIc bacteriocins, which require complementary interaction of two separate peptides. Interestingly, while some streptococci are susceptible to both of the mutacins, most of the strains are not, suggesting that immunity against these two mutacins is different. Mechanisms of immunity against a given bacteriocin can vary widely. The immunity factors can interact directly with the bacteriocin itself, thereby blocking interaction with the membrane receptors, or facilitate expulsion of intracellularly accumulated bacteriocins (9, 20). Another novel mechanism by which immunity protein blocks the interaction of bacteriocin with its cognate membrane receptor is mannose phosphotransferase (man-PTS) (13). Since very little is known about the mode of action for these two mutacins, further studies are required to understand the molecular mechanism of target specificity as well as immunity against the activity of these mutacins.
Acknowledgments
This study was made possible by a NIDCR grant (DE016686) to I.B.
Footnotes
Published ahead of print on 4 February 2011.
REFERENCES
- 1.Aas, J. A., et al. 2008. Bacteria of dental caries in primary and permanent teeth in children and young adults. J. Clin. Microbiol. 46:1407-1417. [DOI] [PMC free article] [PubMed] [Google Scholar]
- 2.Ajdic, D., et al. 2002. Genome sequence of Streptococcus mutans UA159, a cariogenic dental pathogen. Proc. Natl. Acad. Sci. U. S. A. 99:14434-14439. [DOI] [PMC free article] [PubMed] [Google Scholar]
- 3.Alaluusua, S., T. Takei, T. Ooshima, and S. Hamada. 1991. Mutacin activity of strains isolated from children with varying levels of mutants streptococci and caries. Arch. Oral Biol. 36:251-255. [DOI] [PubMed] [Google Scholar]
- 4.Allison, G. E., C. Fremaux, and T. R. Klaenhammer. 1994. Expansion of bacteriocin activity and host range upon complementation of two peptides encoded within the lactacin F operon. J. Bacteriol. 176:2235-2241. [DOI] [PMC free article] [PubMed] [Google Scholar]
- 5.Baba, T., and O. Schneewind. 1998. Instruments of microbial warfare: bacteriocin synthesis, toxicity and immunity. Trends Microbiol. 6:66-71. [DOI] [PubMed] [Google Scholar]
- 6.Banerjee, A., and I. Biswas. 2008. Markerless multiple-gene-deletion system for Streptococcus mutans. Appl. Environ. Microbiol. 74:2037-2042. [DOI] [PMC free article] [PubMed] [Google Scholar]
- 7.Biswas, I., L. Drake, and S. Biswas. 2007. Regulation of gbpC expression in Streptococcus mutans. J. Bacteriol. 189:6521-6531. [DOI] [PMC free article] [PubMed] [Google Scholar]
- 8.Biswas, I., and J. R. Scott. 2003. Identification of rocA, a positive regulator of covR expression in the group A streptococcus. J. Bacteriol. 185:3081-3090. [DOI] [PMC free article] [PubMed] [Google Scholar]
- 9.Chatterjee, C., M. Paul, L. Xie, and W. A. van der Donk. 2005. Biosynthesis and mode of action of lantibiotics. Chem. Rev. 105:633-684. [DOI] [PubMed] [Google Scholar]
- 10.Chattoraj, P., A. Banerjee, S. Biswas, and I. Biswas. 2010. ClpP of Streptococcus mutans differentially regulates expression of genomic islands, mutacin production, and antibiotic tolerance. J. Bacteriol. 192:1312-1323. [DOI] [PMC free article] [PubMed] [Google Scholar]
- 11.Cotter, P. D., C. Hill, and R. P. Ross. 2005. Bacteriocins: developing innate immunity for food. Nat. Rev. Microbiol. 3:777-788. [DOI] [PubMed] [Google Scholar]
- 12.de Vos, W. M., O. P. Kuipers, J. R. van der Meer, and R. J. Siezen. 1995. Maturation pathway of nisin and other lantibiotics: post-translationally modified antimicrobial peptides exported by gram-positive bacteria. Mol. Microbiol. 17:427-437. [DOI] [PubMed] [Google Scholar]
- 13.Diep, D. B., M. Skaugen, Z. Salehian, H. Holo, and I. F. Nes. 2007. Common mechanisms of target cell recognition and immunity for class II bacteriocins. Proc. Natl. Acad. Sci. U. S. A. 104:2384-2389. [DOI] [PMC free article] [PubMed] [Google Scholar]
- 14.Hale, J. D., N. C. Heng, R. W. Jack, and J. R. Tagg. 2005. Identification of nlmTE, the locus encoding the ABC transport system required for export of nonlantibiotic mutacins in Streptococcus mutans. J. Bacteriol. 187:5036-5039. [DOI] [PMC free article] [PubMed] [Google Scholar]
- 15.Hale, J. D., Y. T. Ting, R. W. Jack, J. R. Tagg, and N. C. Heng. 2005. Bacteriocin (mutacin) production by Streptococcus mutans genome sequence reference strain UA159: elucidation of the antimicrobial repertoire by genetic dissection. Appl. Environ. Microbiol. 71:7613-7617. [DOI] [PMC free article] [PubMed] [Google Scholar]
- 16.Hillman, J. D., et al. 1998. Genetic and biochemical analysis of mutacin 1140, a lantibiotic from Streptococcus mutans. Infect. Immun. 66:2743-2749. [DOI] [PMC free article] [PubMed] [Google Scholar]
- 17.Jack, R. W., J. R. Tagg, and B. Ray. 1995. Bacteriocins of gram-positive bacteria. Microbiol. Rev. 59:171-200. [DOI] [PMC free article] [PubMed] [Google Scholar]
- 18.Klaenhammer, T. R. 1993. Genetics of bacteriocins produced by lactic acid bacteria. FEMS Microbiol. Rev. 12:39-85. [DOI] [PubMed] [Google Scholar]
- 19.Loesche, W. J. 1986. Role of Streptococcus mutans in human dental decay. Microbiol. Rev. 50:353-380. [DOI] [PMC free article] [PubMed] [Google Scholar]
- 20.Matsumoto-Nakano, M., and H. K. Kuramitsu. 2006. Role of bacteriocin immunity proteins in the antimicrobial sensitivity of Streptococcus mutans. J. Bacteriol. 188:8095-8102. [DOI] [PMC free article] [PubMed] [Google Scholar]
- 21.Nissen-Meyer, J., P. Rogne, C. Oppegard, H. S. Haugen, and P. E. Kristiansen. 2009. Structure-function relationships of the non-lanthionine-containing peptide (class II) bacteriocins produced by gram-positive bacteria. Curr. Pharm. Biotechnol. 10:19-37. [DOI] [PubMed] [Google Scholar]
- 22.Perez-Casal, J., M. Caparon, and J. Scott. 1992. Introduction of the emm6 gene into an emm-deleted strain of Streptococcus pyogenes restores its ability to resist phagocytosis. Res. Microbiol. 143:549-558. [DOI] [PubMed] [Google Scholar]
- 23.Perry, J. A., M. B. Jones, S. N. Peterson, D. G. Cvitkovitch, and C. M. Levesque. 2009. Peptide alarmone signalling triggers an auto-active bacteriocin necessary for genetic competence. Mol. Microbiol. 72:905-917. [DOI] [PMC free article] [PubMed] [Google Scholar]
- 24.Qi, F., P. Chen, and P. W. Caufield. 1999. Functional analyses of the promoters in the lantibiotic mutacin II biosynthetic locus in Streptococcus mutans. Appl. Environ. Microbiol. 65:652-658. [DOI] [PMC free article] [PubMed] [Google Scholar]
- 25.Qi, F., P. Chen, and P. W. Caufield. 2000. Purification and biochemical characterization of mutacin I from the group I strain of Streptococcus mutans, CH43, and genetic analysis of mutacin I biosynthesis genes. Appl. Environ. Microbiol. 66:3221-3229. [DOI] [PMC free article] [PubMed] [Google Scholar]
- 26.Qi, F., P. Chen, and P. W. Caufield. 1999. Purification of mutacin III from group III Streptococcus mutans UA787 and genetic analyses of mutacin III biosynthesis genes. Appl. Environ. Microbiol. 65:3880-3887. [DOI] [PMC free article] [PubMed] [Google Scholar]
- 27.Qi, F., P. Chen, and P. W. Caufield. 2001. The group I strain of Streptococcus mutans, UA140, produces both the lantibiotic mutacin I and a nonlantibiotic bacteriocin, mutacin IV. Appl. Environ. Microbiol. 67:15-21. [DOI] [PMC free article] [PubMed] [Google Scholar]
- 28.Sahl, H. G., and G. Bierbaum. 1998. Lantibiotics: biosynthesis and biological activities of uniquely modified peptides from gram-positive bacteria. Annu. Rev. Microbiol. 52:41-79. [DOI] [PubMed] [Google Scholar]
- 29.van der Ploeg, J. R. 2005. Regulation of bacteriocin production in Streptococcus mutans by the quorum-sensing system required for development of genetic competence. J. Bacteriol. 187:3980-3989. [DOI] [PMC free article] [PubMed] [Google Scholar]
- 30.Willey, J. M., and W. A. van der Donk. 2007. Lantibiotics: peptides of diverse structure and function. Annu. Rev. Microbiol. 61:477-501. [DOI] [PubMed] [Google Scholar]
- 31.Yamamoto, Y., Y. Togawa, M. Shimosaka, and M. Okazaki. 2003. Purification and characterization of a novel bacteriocin produced by Enterococcus faecalis strain RJ-11. Appl. Environ. Microbiol. 69:5746-5753. [DOI] [PMC free article] [PubMed] [Google Scholar]
- 32.Yonezawa, H., and H. K. Kuramitsu. 2005. Genetic analysis of a unique bacteriocin, Smb, produced by Streptococcus mutans GS5. Antimicrob. Agents Chemother. 49:541-548. [DOI] [PMC free article] [PubMed] [Google Scholar]